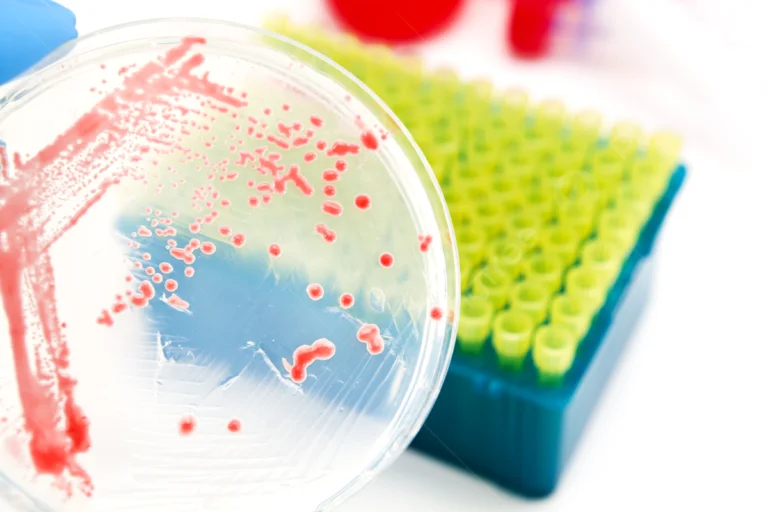
ANÁLISE EM DIAGNÓSTICO IN VITRO

Composição: Xilose, lisina, deoxicolato de sódio, lactose, sacarose, tiossulfato, ferro e ágar.
Função: Isolamento e diferenciação de enterobactérias patogênicas.
Apresentação: Placas estéreis prontas para uso ou meio em pó desidratado.
Embalagem: Identificada por lote, validade e certificado de qualidade.
Indústria Farmacêutica: Ensaios microbiológicos em medicamentos estéreis.
Indústria de Dispositivos Médicos: Controle de esterilidade em materiais hospitalares.
Indústria de Cosméticos: Verificação microbiológica em produtos de uso ocular e mucosas.
Indústria de Biotecnologia: Monitoramento microbiológico de vacinas, hormônios e anticorpos.
Indústria de Alimentos e Bebidas: Detecção de patógenos entéricos em alimentos e água.
Rotulagem com nome do produto, lote, validade e especificação técnica.
Certificado de esterilidade e controle de qualidade incluso.
Meios complementares para confirmação: Ágar SS, Ágar Hektoen, Ágar MacConkey.
Kits bioquímicos para diferenciação final de enterobactérias.
Não aplicável (produto físico).
WhatsApp us